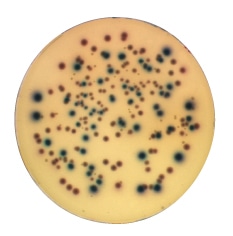

食品微生物検査の手順
(大腸菌群・大腸菌)
もくじ
1.デソキシコレート寒天培地(大腸菌群)
2.BGLB液体培地(大腸菌群)
3.EC液体培地(糞便系大腸菌群および大腸菌)/MPN法
4.合成酵素基質培地
5.大腸菌群検査のための培地選定
6.最確数表
7.微生物検査を始めたい企業様へ
1.デソキシコレート寒天培地(大腸菌群)
2.BGLB液体培地(大腸菌群)
3.EC液体培地(糞便系大腸菌群および大腸菌)/MPN法
4.合成酵素基質培地
5.大腸菌群検査のための培地選定
6.最確数表
7.微生物検査を始めたい企業様へ
デソキシコレート寒天培地(大腸菌群)
手順1
各希釈段階につき2枚のシャーレに、調製した検体液1mlずつ注入します。
手順2
45~50℃に保温しておいたデソキシコレート寒天培地を約15~20ml各シャーレに分注し、検体液と混合させます。培地表面での拡散集落を防ぐため、及び大腸菌群が定型的な集落を形成するように、寒天が固まってから、さらに培地を薄く重層します。


8の字に円を描く。シャーレをまわす。
手順3
シャーレを倒置して、インキュベーターに入れ、35±1℃で20±2時間培養します。
一般生菌数と同じように計測します。
手順4
EMB寒天培地上に生育した集落を確認し、金属光沢のある黒色コロニーが認められた場合「大腸菌群確定試験陽性」として完全試験を行います。BGLB液体培地で検査を行った場合は、陽性試験管の数よりMPN値を求めます。
集落の生育が認められない場合や、定型的集落が認められない場合は、大腸菌群陰性とします。


①デソキシコレート寒天での平板上の定型的集落を釣菌します。
②BGLBブイヨンでの推定試験でガス発生陽性試験管を1白金耳量採取します。
③EMB寒天培地に画線塗抹し、35±1℃、24±2時間培養します。
手順5
定型的集落を標準寒天斜面培地に接種し、35±1℃ 24±2時間まで培養します。発育したコロニーをグラム染色し、検鏡します。

発育した集落をグラム染色・検鏡し、グラム陰性・無芽胞桿菌⇒大腸菌群陽性
BGLB液体培地(大腸菌群)
手順1
検体液(10倍希釈液)を10ml、倍濃度のBGLBブイヨン3本に接種します。同じく検体液を1ml、100倍段階希釈液を1ml、通常濃度のBGLBブイヨン3本に接種します。

手順2
35±1℃のインキュベーターで24~48±3時間培養します。手順3
ダーラム管中のガス発生の有無を確認します(ガス発生が見られない場合は、試験管を軽く振って再度確認します)。
48時間まで培養しても、ガスの発生が認められなければ「大腸菌群陰性」とします(検査終了)。
培養開始後24時間でガス発生を確認し、ガス発生があれば「推定試験陽性」とし、次の試験に進みます。 定量管理の場合は最画数表に当てはめ、1gあたりのMPN値を求めます。
定量管理の場合は最画数表に当てはめ、1gあたりのMPN値を求めます。
48時間まで培養しても、ガスの発生が認められなければ「大腸菌群陰性」とします(検査終了)。
培養開始後24時間でガス発生を確認し、ガス発生があれば「推定試験陽性」とし、次の試験に進みます。

手順4
EMB寒天培地上に生育した集落を確認し、金属光沢のある黒色コロニーが認められた場合「大腸菌群確定試験陽性」として完全試験を行います。BGLB液体培地で検査を行った場合は、陽性試験管の数よりMPN値を求めます。
集落の生育が認められない場合や、定型的集落が認められない場合は、大腸菌群陰性とします。


①デソキシコレート寒天での平板上の定型的集落を釣菌します。
②BGLBブイヨンでの推定試験でガス発生陽性試験管を1白金耳量採取します。
③EMB寒天培地に画線塗抹し、35±1℃、24±2時間培養します。
手順5
定型的集落を乳糖ブイヨン発酵管に接種し、35±1℃ 24~48±3時間まで培養します。
ガス産生が認められる⇒大腸菌群陽性
EC液体培地(糞便系大腸菌群および大腸菌)/MPN法
手順1
検体液(10倍希釈液)を10ml、倍濃度のECブイヨン3本に接種します。同じく検体液を1ml、100倍段階希釈液を1ml、通常濃度のECブイヨン3本に接種します。

手順2
44.5±0.2℃の恒温水槽で24±2時間培養します。手順3
ダーラム管中のガス発生の有無を確認します(ガス発生が見られない場合は、試験管を軽く振って再度確認します)。24時間まで培養しても、ガスの発生が認められなければ「糞便系大腸菌群陰性」とします(検査終了)。
培養開始後24時間でガス発生を確認し、ガス発生があれば「推定試験陽性」とし、次の試験に進みます。

手順4

②EMB寒天培地に画線塗抹し、35±1℃、24±2時間培養します。

平板上に生育した集落を確認し、金属光沢のある黒色コロニーが認められた場合「糞便系大腸菌群確定試験陽性」として完全試験を行います。
陽性試験管の数より糞便系大腸菌群MPN値を求めます。
集落の生育が認められない場合や、定型的集落が認められない場合は「糞便系大腸菌群確定試験陰性」とします。
陽性試験管の数より糞便系大腸菌群MPN値を求めます。
集落の生育が認められない場合や、定型的集落が認められない場合は「糞便系大腸菌群確定試験陰性」とします。
手順5
【IMVIC反応】以下のような結果の得られた試験管より大腸菌(E.coli)MPN値を求めます。
合成酵素基質培地
合成酵素基質培地は、従来の確定試験、完全試験の必要がないため大腸菌群の簡易・迅速検査に有効な方法です。




手順1
各希釈段階につき2枚のシャーレに、調整した検体液1mlずつ注入します。
手順2
45~50℃に保温したクロモカルトコリフォーム寒天培地を約15~20ml各シャーレに分注し、検体液と混合させます。
手順3
シャーレを倒置して、インキュベーターに入れ、35~37℃で24時間培養します。
培地に発育したコロニーを計測し、一般生菌数と同じように計測します。 【大腸菌群・E.coli】
合成酵素基質培地
(クロモカルトコリフォーム寒天)
青/E.coli
赤/E.coli以外の大腸菌群
合成酵素基質培地
(クロモカルトコリフォーム寒天)
青/E.coli
赤/E.coli以外の大腸菌群
大腸菌群検査のための培地選定
| 検査項目 | 食品別 | 使用培地 |
| 大腸菌群 | アイスクリーム類 | デソキシコレート寒天培地 |
| はっ酵乳、乳酸菌飲料 | デソキシコレート寒天培地 | |
| バター、バターオイル、 プロセスチーズ、濃縮ホエイ |
デソキシコレート寒天培地 | |
| 上記以外の乳・乳製品 | BGLB培地 | |
| 氷雪、清涼飲料水、 粉末清涼飲料 |
LB培地 | |
| 氷菓 | デソキシコレート寒天培地 | |
| 食肉製品(包装後加熱)、 鯨肉製品、魚肉ねり製品 |
BGLB培地 | |
| 冷凍ゆでたこ、 生食用冷凍鮮魚介 |
デソキシコレート寒天培地 | |
| 冷凍食品(無加熱、 凍結前加熱済み:加熱後摂取) |
デソキシコレート寒天培地 |
最確数表
| 陽性管数 | 係数 | 陽性管数 | 係数 | 陽性管数 | 係数 | 陽性管数 | 係数 | ||||||||
| A | B | C | A | B | C | A | B | C | A | B | C | ||||
| 0 | 0 | 0 | <3.0 | 1 | 0 | 0 | 3.6 | 2 | 0 | 0 | 9.1 | 3 | 0 | 0 | 23 |
| 0 | 0 | 1 | 3.0 | 1 | 0 | 1 | 7.2 | 2 | 0 | 1 | 14 | 3 | 0 | 1 | 39 |
| 0 | 0 | 2 | 6.0 | 1 | 0 | 2 | 11 | 2 | 0 | 2 | 20 | 3 | 0 | 2 | 64 |
| 0 | 0 | 3 | 9.0 | 1 | 0 | 3 | 15 | 2 | 0 | 3 | 26 | 3 | 0 | 3 | 95 |
| 0 | 1 | 0 | 3.0 | 1 | 1 | 0 | 7.3 | 2 | 1 | 0 | 15 | 3 | 1 | 0 | 43 |
| 0 | 1 | 1 | 6.1 | 1 | 1 | 1 | 11 | 2 | 1 | 1 | 20 | 3 | 1 | 1 | 75 |
| 0 | 1 | 2 | 9.2 | 1 | 1 | 2 | 15 | 2 | 1 | 2 | 27 | 3 | 1 | 2 | 120 |
| 0 | 1 | 3 | 12 | 1 | 1 | 3 | 19 | 2 | 1 | 3 | 34 | 3 | 1 | 3 | 160 |
| 0 | 2 | 0 | 6.2 | 1 | 2 | 0 | 11 | 2 | 2 | 0 | 21 | 3 | 2 | 0 | 93 |
| 0 | 2 | 1 | 9.3 | 1 | 2 | 1 | 15 | 2 | 2 | 1 | 28 | 3 | 2 | 1 | 150 |
| 0 | 2 | 2 | 12 | 1 | 2 | 2 | 20 | 2 | 2 | 2 | 35 | 3 | 2 | 2 | 210 |
| 0 | 2 | 3 | 16 | 1 | 2 | 3 | 29 | 2 | 2 | 3 | 42 | 3 | 2 | 3 | 290 |
| 0 | 3 | 0 | 9.4 | 1 | 3 | 0 | 16 | 2 | 3 | 0 | 29 | 3 | 3 | 0 | 240 |
| 0 | 3 | 1 | 13 | 1 | 3 | 1 | 20 | 2 | 3 | 1 | 36 | 3 | 3 | 1 | 460 |
| 0 | 3 | 2 | 16 | 1 | 3 | 2 | 24 | 2 | 3 | 2 | 44 | 3 | 3 | 2 | 1,100 |
| 0 | 3 | 3 | 19 | 1 | 3 | 3 | 29 | 2 | 3 | 3 | 53 | 3 | 3 | 3 | <1,400 |
B・・・検体の100倍希釈液を1ml接種したもの
C・・・検体の100倍希釈液を0.1ml接種したもの
微生物検査を始めたい企業様へ

食品微生物検査キットDDSマスターⅢは、微生物検査に必要な機器を取り揃えた初歩的なキットです。
D(どこでも)、D(誰でも)、S(すぐできる)の名の通り、初めての方でも簡単に微生物検査が行えます。
このセットを使用すれば限られたスペースでも自主検査(微生物検査)がスタートできます。
※DDSキットは5~10検体/日の検体数を目安にしております。
それ以上の検体数や、検査する対象の菌種が多岐にわたる場合、ご相談ください。



